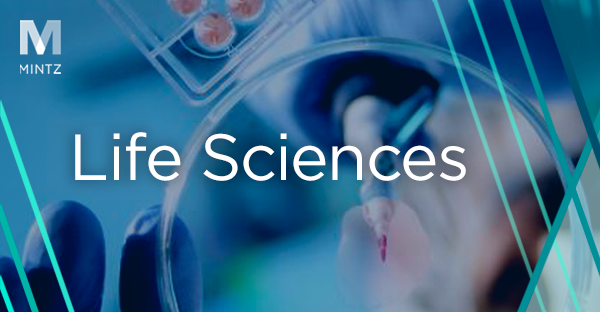
Life Sciences Viewpoints Thumbnail

Life Sciences
Viewpoints
Filter by:
FDA in Flux — January 2026 Newsletter
January 22, 2026 | Article | By Joanne Hawana, Benjamin Zegarelli
The January 2026 edition of FDA in Flux highlights significant developments shaping the regulatory landscape for medical, life sciences, and consumer product sectors.
Perspectives on JPM 2026
January 20, 2026 | Blog | By Cheryl V. Reicin
Cheryl Reicin, International Chair of Life Sciences, shares her perspectives on this year’s JPM Healthcare Conference, that reflected renewed optimism in life sciences dealmaking, with strong public‑market activity and growing interest in key subsectors.
FDA in Flux — December 2025 Newsletter
December 16, 2025 | Article | By Joanne Hawana, Benjamin Zegarelli
The December 2025 edition of FDA in Flux highlights significant developments shaping the regulatory landscape for medical, life sciences, and consumer product sectors.
FDA in Flux — November 2025 Newsletter
November 19, 2025 | Article | By Joanne Hawana, Benjamin Zegarelli
The November 2025 edition of FDA in Flux highlights significant developments shaping the regulatory landscape for medical, life sciences, and consumer product sectors.
FDA in Flux – October 2025 Newsletter
October 16, 2025 | Article | By Joanne Hawana, Benjamin Zegarelli
The October 2025 edition of FDA in Flux highlights significant developments shaping the regulatory landscape for medical, life sciences, and consumer product sectors.
FDA in Flux — September 2025 Newsletter
September 17, 2025 | Article | By Joanne Hawana, Benjamin Zegarelli
The September 2025 edition of FDA in Flux highlights significant developments shaping the regulatory landscape for medical, life sciences, and consumer product sectors.
FDA in Flux — August 2025 Newsletter
August 14, 2025 | Article | By Joanne Hawana, Benjamin Zegarelli
The August 2025 edition of FDA in Flux highlights significant developments shaping the regulatory landscape for medical, life sciences, and consumer product sectors. Responding to President Trump’s executive order on reducing regulatory burdens, FDA announced the PreCheck program, with the goal of accelerating onshoring of drug manufacturing. FDA, HHS, and USDA have issued a joint request for data and information to develop a uniform definition of ultra-processed foods (UPF). FDA held a public meeting on August 4 to start negotiation for reauthorizing the Medical Device User Fee Amendments (MDUFA), providing a look at what stakeholders hope to achieve in terms of FDA commitments and performance goals. In July, FDA announced that it is revoking 52 individual “obsolete and unnecessary” food product standard-of-identity (SOI) regulations.
FDA in Flux — July 2025 Newsletter
July 9, 2025 | Article | By Joanne Hawana, Benjamin Zegarelli
The July 2025 edition of FDA in Flux highlights five significant developments shaping the regulatory landscape for medical, life sciences, and consumer product sectors.
FDA in Flux — June 2025 Newsletter
June 12, 2025 | Article | By Joanne Hawana, Benjamin Zegarelli
Welcome to FDA in Flux – A Mintz newsletter tracking rapid changes in policy and agency actions that impact medical, life sciences, and consumer product investment decisions and development strategies.
Between the Biotech Waves Conversation with William Hicks
April 16, 2025 | Podcast
Life Science Dealmaking Trends 2025
January 8, 2025 | Video | By Cheryl V. Reicin
Employers and company owners should stay informed of the 2025 life science dealmaking trends. In a series of videos, International Chair of Life Sciences Cheryl Reicin provides valuable commentary on Big Pharma M&A, deal drivers, patent cliff impacts, and emerging sectors.
The Life Sci Fantastic Podcast - The Business of Biotech
November 28, 2024 | Podcast
Why companies may want to accelerate marketing approval for their patented drugs in Canada
November 8, 2024 | Blog | By Lee Johnson, PhD, Christine C. Pemberton, PhD
New Schedule 13G Accelerated Filing Deadlines Effective Today, September 30, 2024
September 30, 2024 | Alert | By Page R. Hubben, Daniel T. Kajunski, Anne Bruno
Read about the new accelerated filing deadlines for ownership reporting on Schedule 13G that take effect on September 30, 2024 and the requirements for different types of investors.
New Biden Executive Order Emphasizes Women’s Health
March 27, 2024 | Alert | By Pamela Mejia, Anthony DeMaio
On March 18, President Biden signed an executive order (EO) that contributes to the administration’s objective to create solutions to long-lasting women’s health issues that have been historically understudied and under-evaluated.
FDA Needs a New Approach to AI/ML-Enabled Medical Devices
March 12, 2024 | Blog | By Benjamin Zegarelli
We have been writing about software as a medical device (SaMD) for years, tracking the Food and Drug Administration's (FDA) efforts to keep up with the fast-paced development of digital technology, such as launching the Digital Health Center of Excellence, implementing predetermined change control plans, and issuing various digital health guidances on device software functions, clinical decision support software, cybersecurity, and other topics. In anticipation of FDA’s Artificial Intelligence /Machine Learning (AI/ML) Medical Devices Workshop in October 2021, we posted a brief history of the agency’s regulatory oversight of software through the traditional medical device regulatory framework established in the 1970s, in which we highlighted the numerous challenges associated with such an approach. But now, with the rise of artificial intelligence and machine learning and the proliferation of AI/ML-enabled software throughout the health care industry, FDA is facing enormous challenges using an outdated, procrustean regulatory framework to maintain standards of safety and quality for such software devices. It is becoming increasingly clear that innovation in the AI/ML and digital health technology space is advancing rapidly, as FDA Commissioner Rob Califf has emphasized in many recent public appearances, and that the traditional device framework is quickly becoming unworkable for such technologies.
ARPA-H Commits $100 Million to Accelerate Women’s Health Research through Sprint for Women’s Health
February 28, 2024 | Alert | By Pamela Mejia, Sarah C. Palmer, Anthony DeMaio
Read about Sprint for Women’s Health, a first-of-its-kind initiative to commit $100 million for research and development in women’s health, announced by the Advanced Research Projects Agency for Health.
Frequently Asked Questions for Private Companies Considering a Reverse Merger
February 13, 2024 | Article | By William Hicks, John T. Rudy
Reverse mergers aren’t an alternative to an IPO, rather they can be a strategic approach for companies looking to go public by leveraging “fallen angels”. Mintz Members Bill Hicks and John Rudy answer frequently asked questions for private companies considering a reverse merger in an article featured in PitchBook’s 2023 Annual US VC Valuations Report. The authors detail the benefits and challenges associated with a reverse merger including finding partners, PIPE financing, Nasdaq access for non-US companies, and SEC implications.
Deal Activity Takeaways from JPM 2024
January 19, 2024 | Blog | By William Whelan
Top 5 Takeaways from JPM 2024
January 12, 2024 | Blog | By Cheryl V. Reicin
J.P. Morgan Healthcare Conference (JPM) is one of the industry’s most important life science investment conferences of the year. Learn more about Cheryl Reicin's top five takeaways from the event.
Explore Other Viewpoints:
- Data Centers & Digital Infrastructure
- AI: The Washington Report
- Antitrust and Federal Regulation
- Appellate
- Arbitration, Mediation & Alternate Dispute Resolution
- Artificial Intelligence
- Awards
- Bankruptcy & Restructuring
- California Land Use
- Cannabis
- Class Action
- Complex Commercial Litigation
- Construction
- Consumer Product Safety
- Corporate Governance (ESG)
- Cross-Border Asset Recovery
- DEI Legal Developments
- Debt Financing
- Direct Investing (M&A)
- Diversity
- EB-5 Financing
- Education & Nonprofits
- Employment
- EnforceMintz
- Environmental (ESG)
- Environmental Enforcement Defense
- Environmental Law
- Environmental, Social, and Corporate Governance (ESG)
- FDA Regulatory
- FDA in Flux
- False Claims Act
- Federal Circuit Appeals
- Financial Institution Litigation
- Government Law
- Growth Equity
- Health Care
- Health Care Compliance, Fraud and Abuse, & Regulatory Counseling
- Health Care Enforcement & Investigations
- Health Care Transactions
- Health Information Privacy & Security
- IP Due Diligence
- IPRs & Other Post Grant Proceedings
- Immigration
- Impacts of a New US Administration
- Insolvency & Creditor Rights Litigation
- Institutional Investor Class Action Recovery
- Insurance & Financial Services
- Insurance Consulting & Risk Management
- Insurance and Reinsurance Problem-Solving & Dispute Resolution
- Intellectual Property
- Investment Funds
- Israel
- Licensing & Technology Transactions
- Life Sciences
- Litigation & Investigations
- M&A Litigation
- ML Strategies
- Managed Care
- Medicare, Medicaid and Commercial Coverage & Reimbursement
- Mergers & Acquisitions
- Patent Litigation
- Patent Prosecution & Strategic Counseling
- Pharmacy Benefits and PBM Contracting
- Portfolio Companies
- Privacy & Cybersecurity
- Private Client
- Private Equity
- Pro Bono
- Probate & Fiduciary Litigation
- Products Liability & Complex Tort
- Projects & Infrastructure
- Public Finance
- Real Estate Litigation
- Real Estate Transactions
- Real Estate, Construction & Infrastructure
- Retail & Consumer Products
- Securities & Capital Markets
- Securities Litigation
- Social (ESG)
- Special Purpose Acquisition Company (SPACs)
- Sports & Entertainment
- State Attorneys General
- Strategic IP Monetization & Licensing
- Sustainable Energy & Infrastructure
- Tax
- Technology
- Technology, Communications & Media
- Technology, Communications & Media Litigation
- Trade Secrets
- Trademark & Copyright
- Trademark Litigation
- Unified Patent Court (UPC)
- Value-Based Care
- Venture Capital & Emerging Companies
- White Collar Defense & Government Investigations
- Women's Health and Technology